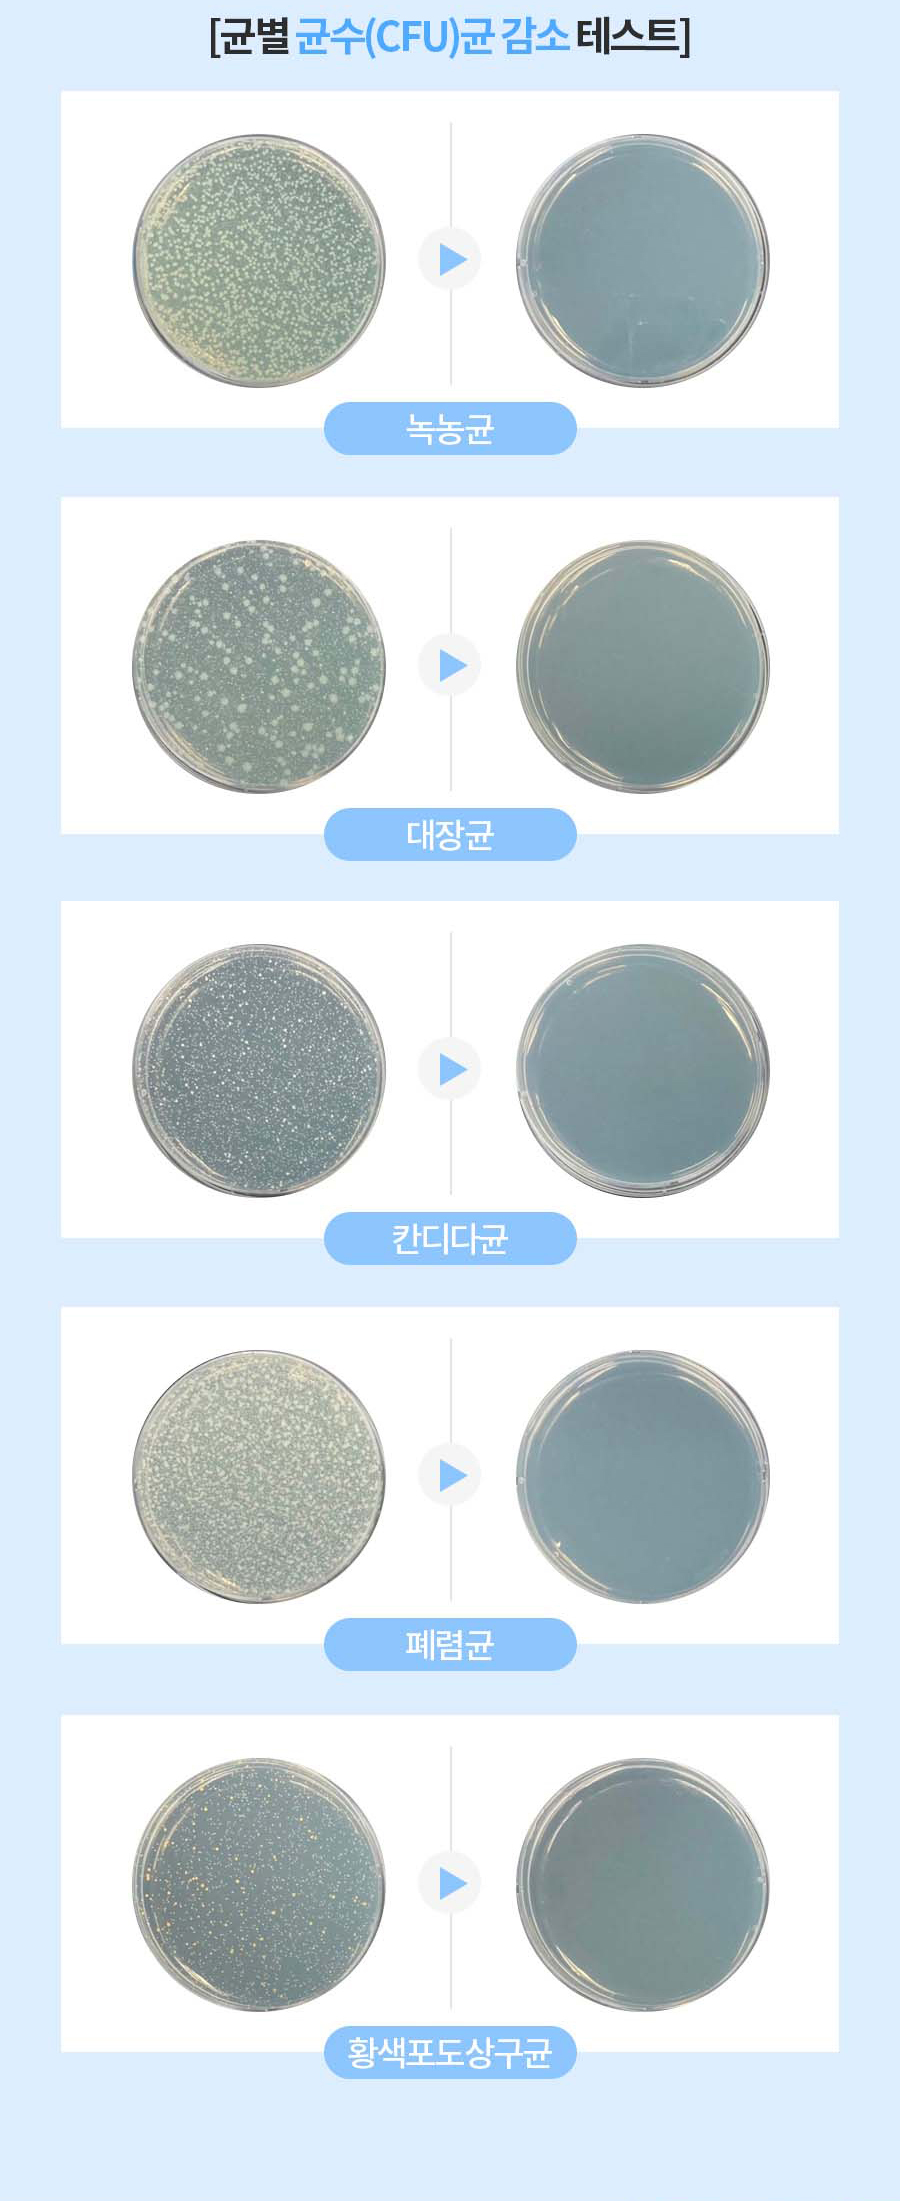

- [유토렉스] 프리미엄 더블케어 UV 히팅건조 듀얼 칫솔살균기 UTC-62VW
- [대명 여울빛 시장]
23%
50,500
39,000
원 판매가
- 제조사
- 유토렉스
- 원산지
- 중국
- 배송정보
-
무료배송

| 소재 | 폴리100% |
| 색상 | 화이트, 핑크, 네이비 |
| 치수 | 상세페이지 참조 |
| 제조사(수입품의 경우 수입자를 함께표기) | 임부복닷컴 |
| 원산지 | 한국 |
| 세탁방법 및 취급시 주의사항 | 드라이크리닝,손세탁(단독세탁) |
| 제조년월 | 2015년도 |
| 품질보증기준 | 구입후 일주일이내 단순변심, 상품하자시 교환,반품 가능.(레깅스,속옷은 착용후 교환반품 불가상품) |
| A/S책임자와 전화번호 | 임부복닷컴 02-2661-5710 |
판매자 정보
- 상호명
- (주)팔도상회
- 대표전화
- 02-802-3388
- 대표자
- 김혜경
- 사업자등록번호
- 563-81-00515
- 대표 이메일
- 8doshop@naver.com
- 통신판매업신고번호
- 2016-서울금천-0965
- 사업장 소재지
- 서울특별시 금천구 시흥대로 52길 16, 2층 팔도상회
배송 정보
- 지정택배사
- 기본배송비
- 무료배송
구매/배송
※ 상품정보에 별도 기재된 경우, 아래의 내용보다 우선하여 적용됩니다.
고액결제의 경우 안전을 위해 카드사에서 확인전화를 드릴 수도 있습니다. 확인과정에서 도난 카드의 사용이나 타인 명의의 주문등 정상적인 주문이 아니라고 판단될 경우 임의로 주문을 보류 또는 취소할 수 있습니다.
무통장 입금은 상품 구매 대금은 PC뱅킹, 인터넷뱅킹, 텔레뱅킹 혹은 가까운 은행에서 직접 입금하시면 됩니다.
주문시 입력한 입금자명과 실제입금자의 성명이 반드시 일치하여야 하며, 7일 이내로 입금을 하셔야 하며 입금되지 않은 주문은 자동취소 됩니다.
교환/반품/환불 가능
※ 상품정보에 별도 기재된 경우, 아래의 내용보다 우선하여 적용됩니다.
교환 및 반품 주소
교환 및 반품이 가능한 경우
- 상품 수령 후 7일 이내에 신청하실 수 있습니다. 단, 제품이 표시·광고 내용과 다르거나, 계약과 다르게 이행된 경우는 제품 수령일부터 3개월 이내, 그 사실을 안 날 또는 알 수 있었던 날부터 30일 이내에 교환/반품이 가능합니다.
교환 및 반품이 불가능한 경우
- 소비자의 책임 있는 사유로 상품 등이 멸실 또는 훼손된 경우 (단지, 상품 확인을 위한 포장 훼손 제외)
- 소비자의 사용 또는 소비에 의해 상품 등의 가치가 현저히 감소한 경우
- 시간의 경과에 의해 재판매가 곤란할 정도로 상품 등의 가치가 현저히 감소한 경우
- 복제가 가능한 상품 등의 포장을 훼손한 경우
- 소비자의 주문에 따라 개별적으로 생산되는 상품이 제작에 들어간 경우
(자세한 내용은 고객만족센터 1:1 E-MAIL상담을 이용해 주시기 바랍니다.)
※ 고객님의 마음이 바뀌어 교환, 반품을 하실 경우 상품반송 비용은 고객님께서 부담하셔야 합니다.

![[유토렉스] 프리미엄 더블케어 UV 히팅건조 듀얼 칫솔살균기 UTC-62VW](https://8doshop.co.kr/product/ext1/2510089052270/s.jpg)








